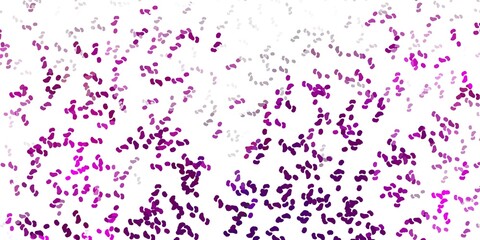
Fototapeta premium Light pink vector pattern with abstract shapes.

RABAT DO 40% - wygasa 23.04 !!! | Darmowa dostawa od 290zł | Potrzebujesz pomocy? Zadzwoń 22 678 07 67
(0)
Produkt dodany poprawnie do Twojego koszyka
Ilość
Razem
Ilość produktów w Twoim koszyku: 0. Jest 1 produkt w Twoim koszyku.
Razem produkty:
Dostawa: Do ustalenia
Razem
Kontynuuj zakupy Przejdź do realizacji zamówienia
Start > Fototapeta premium
Jakiego obrazu szukasz?
Użyj wyszukiwarki i szukaj wśród milionów zdjęć.
Fototapety Fototapeta premium
- #371403410
- #1764388733
- #1718165120